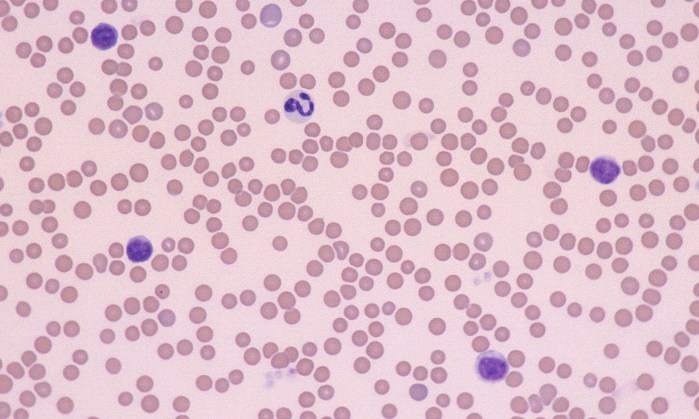
CLL 5 (Feline 1)

CLL

Chronic lymphocytic leukemia (CLL): increased numbers of small mature lymphocytes with normal morphology on blood smear. CLL may look identical to non-neoplastic lymphocytosis on visual evaluation (non-neoplastic causes of lymphocytosis must be ruled out).